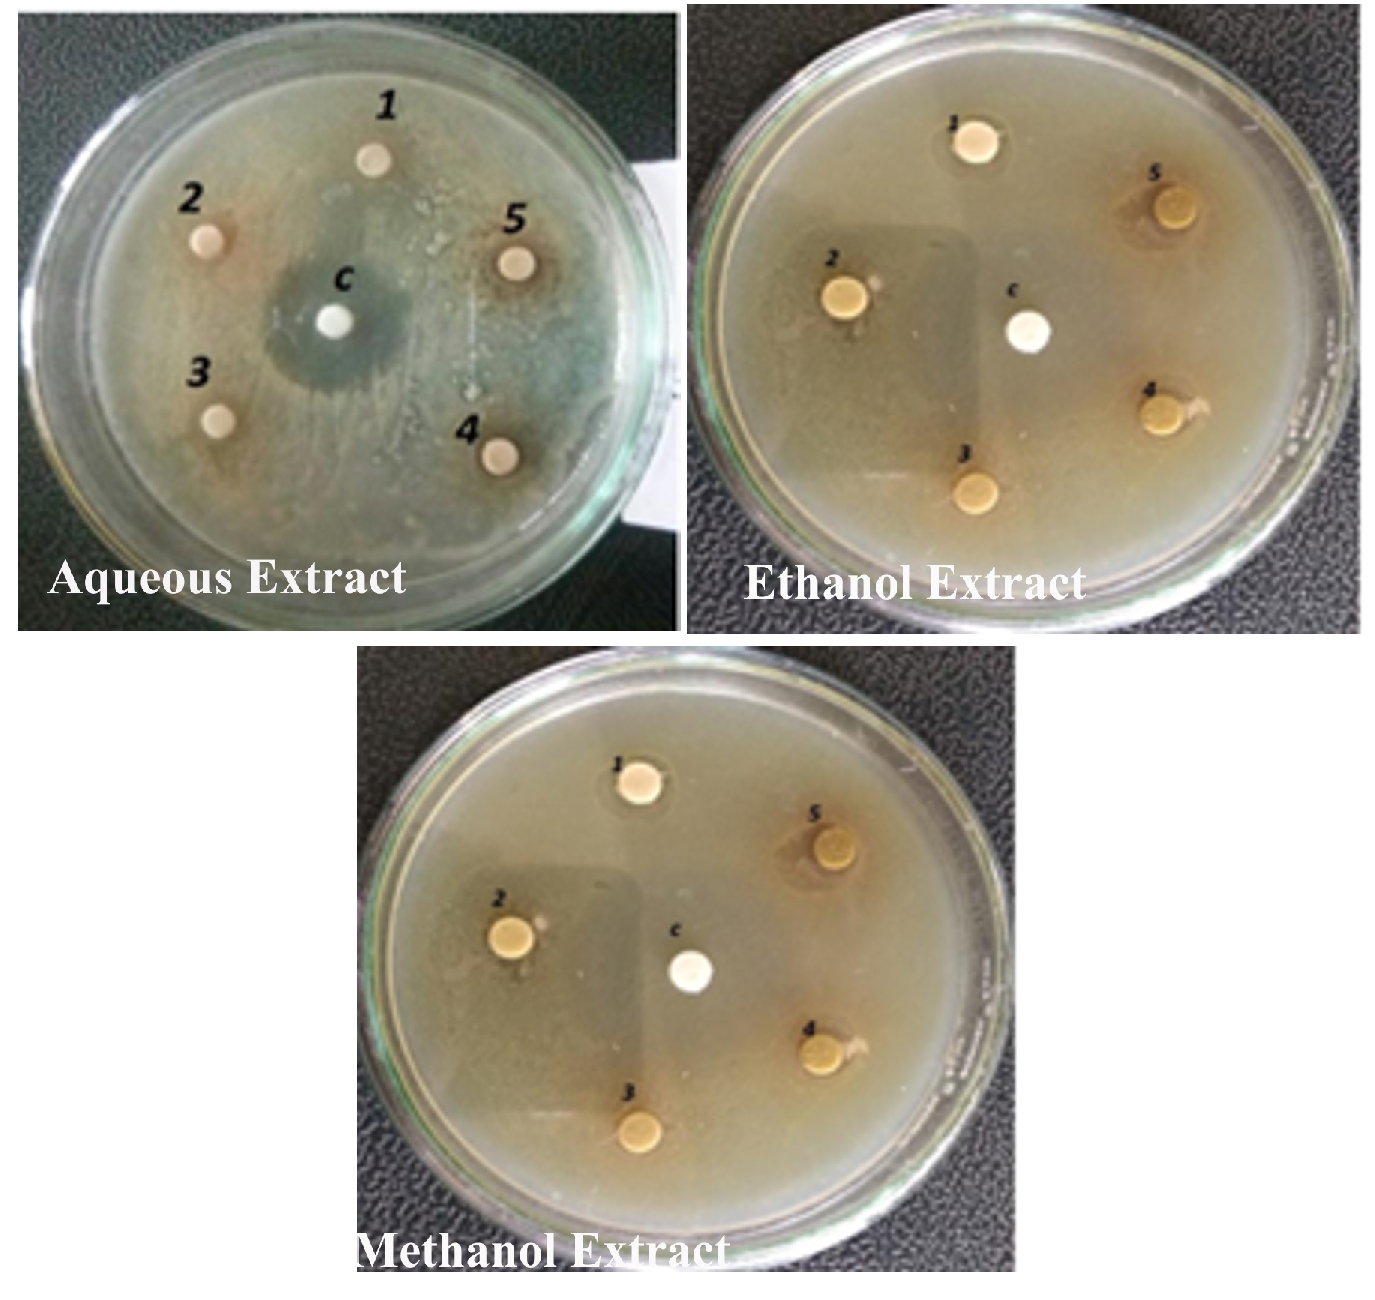
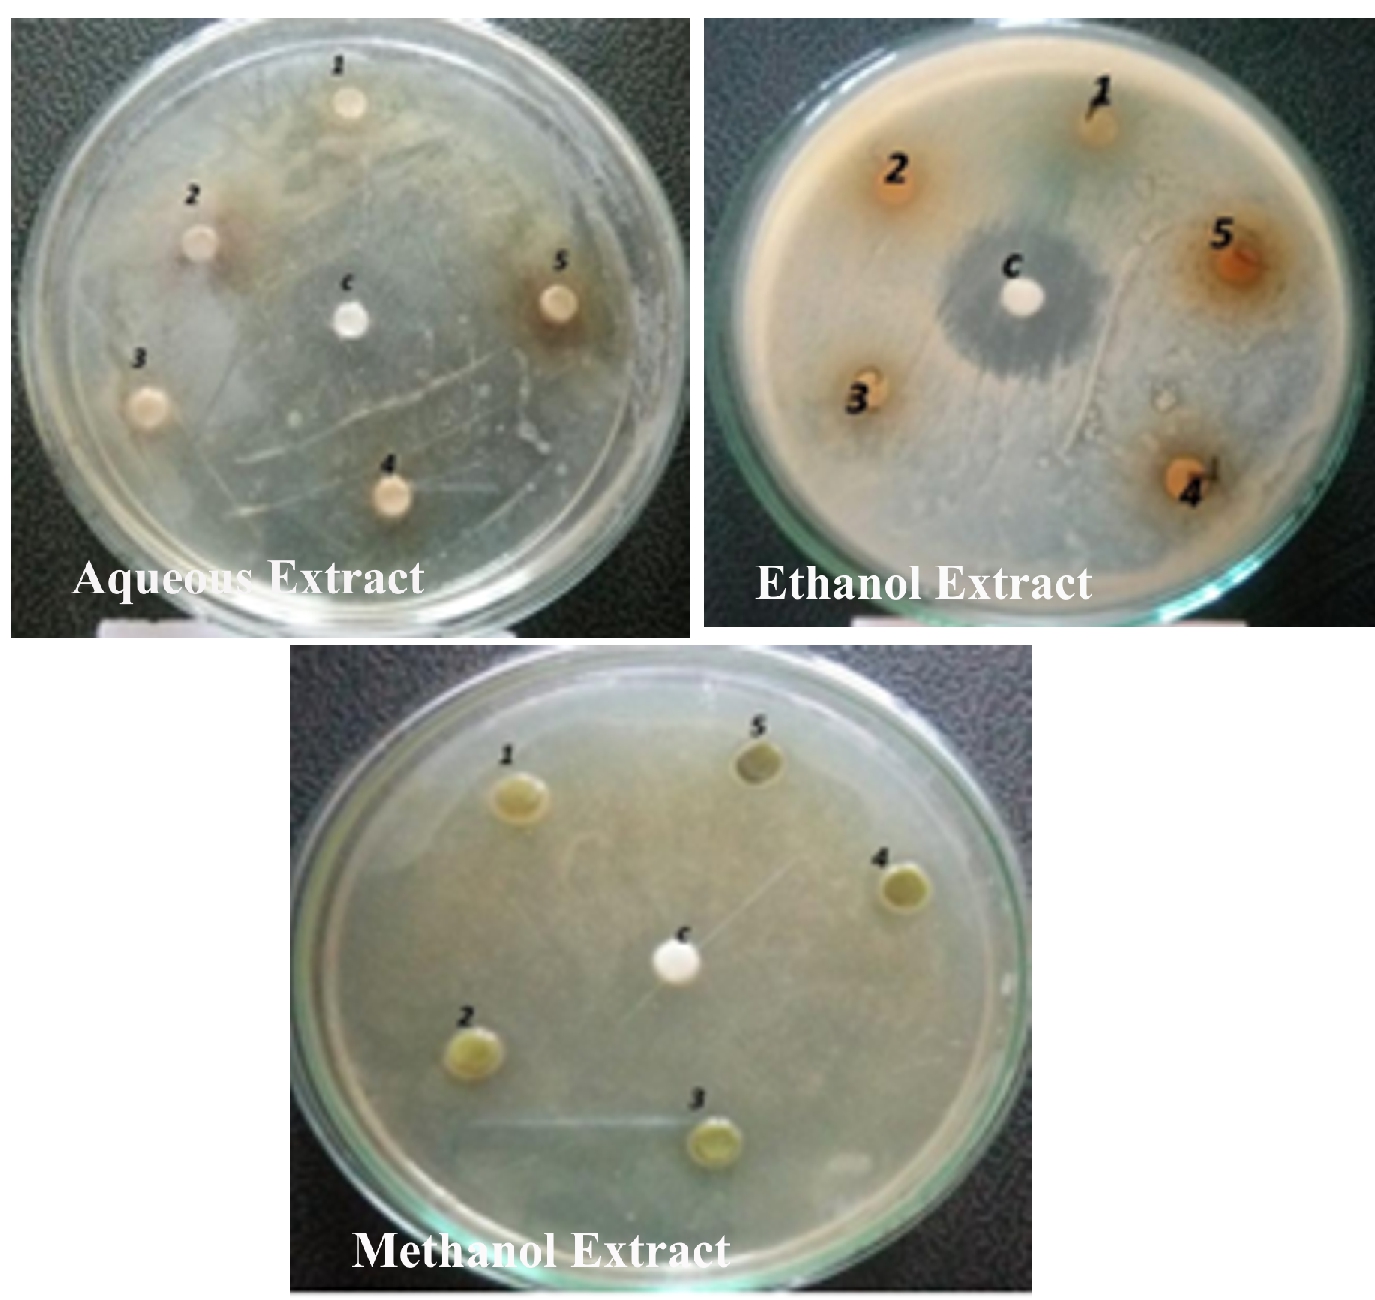
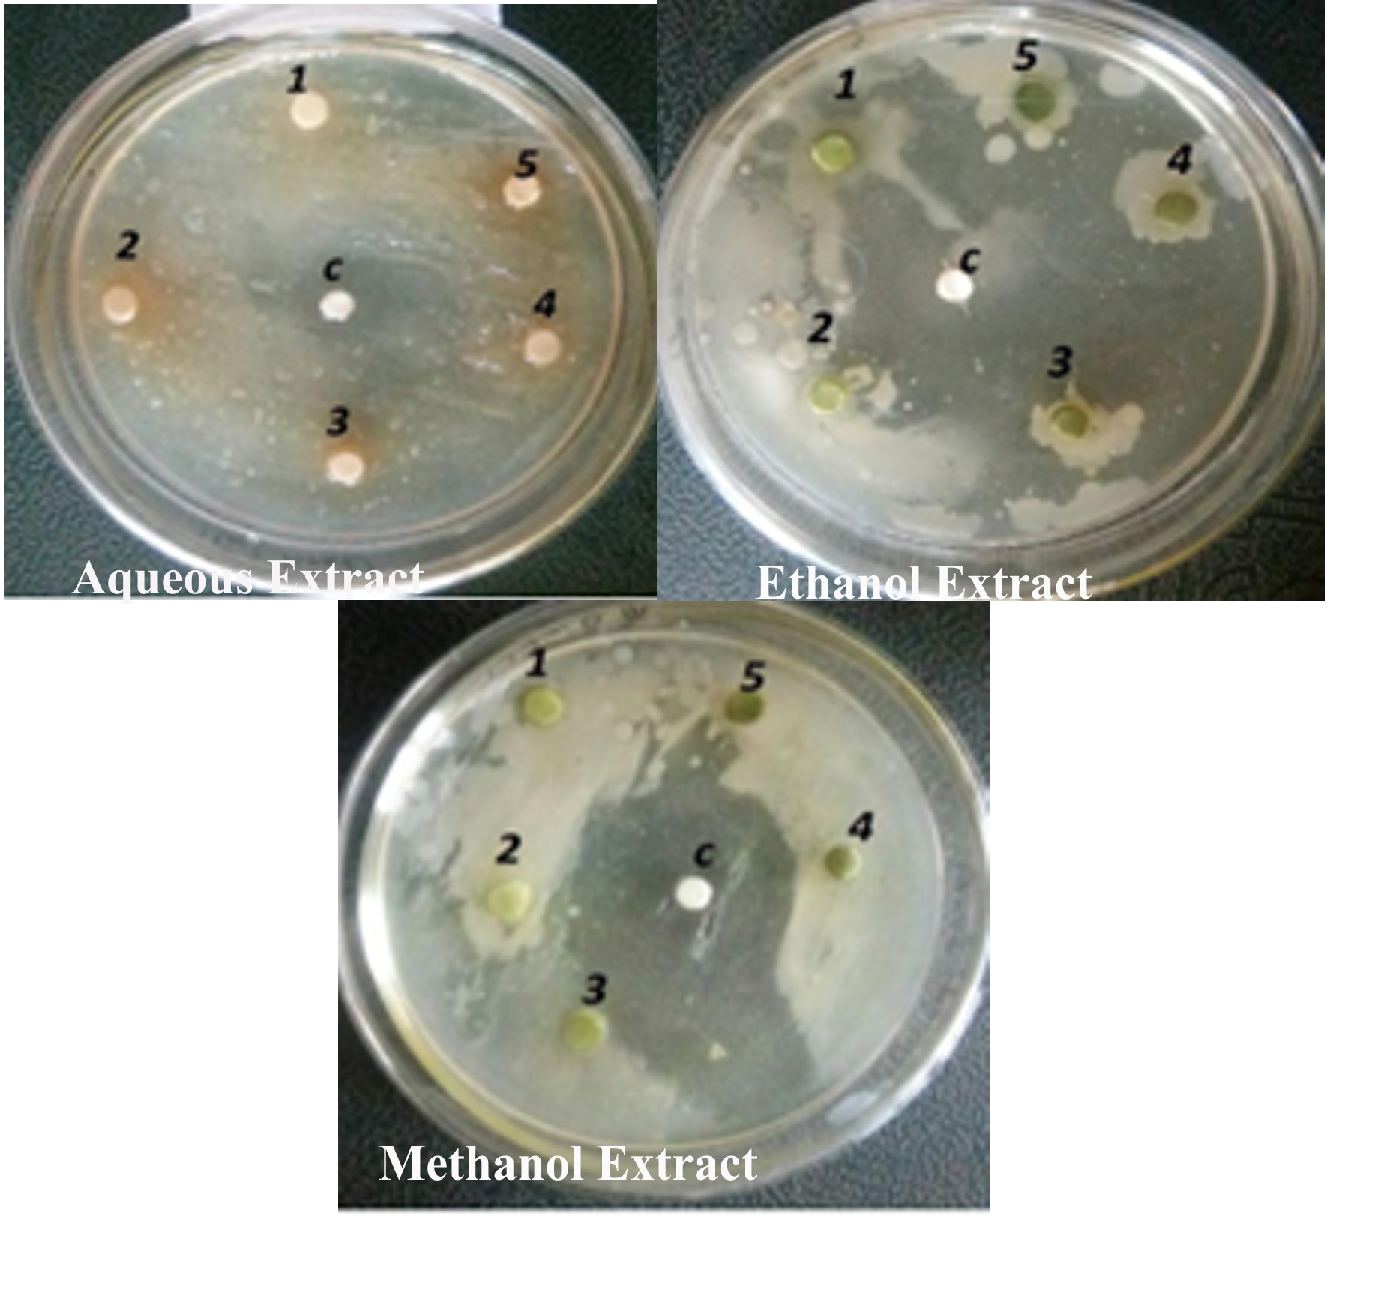
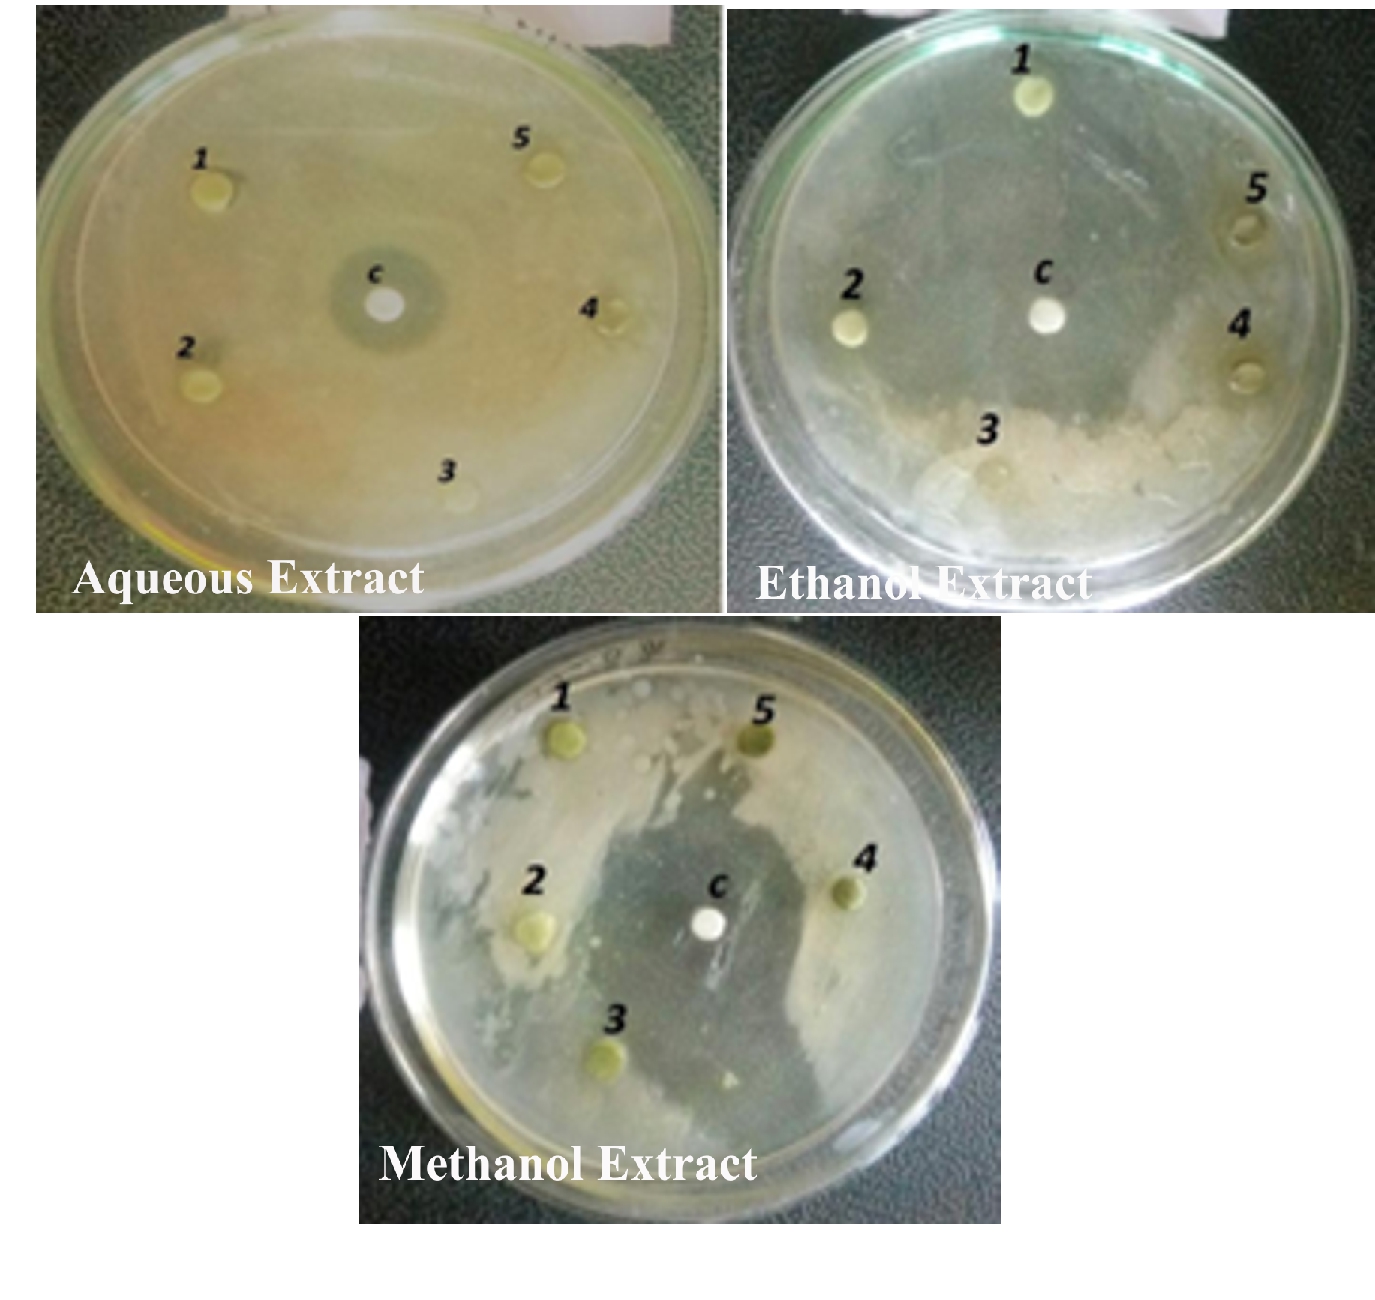
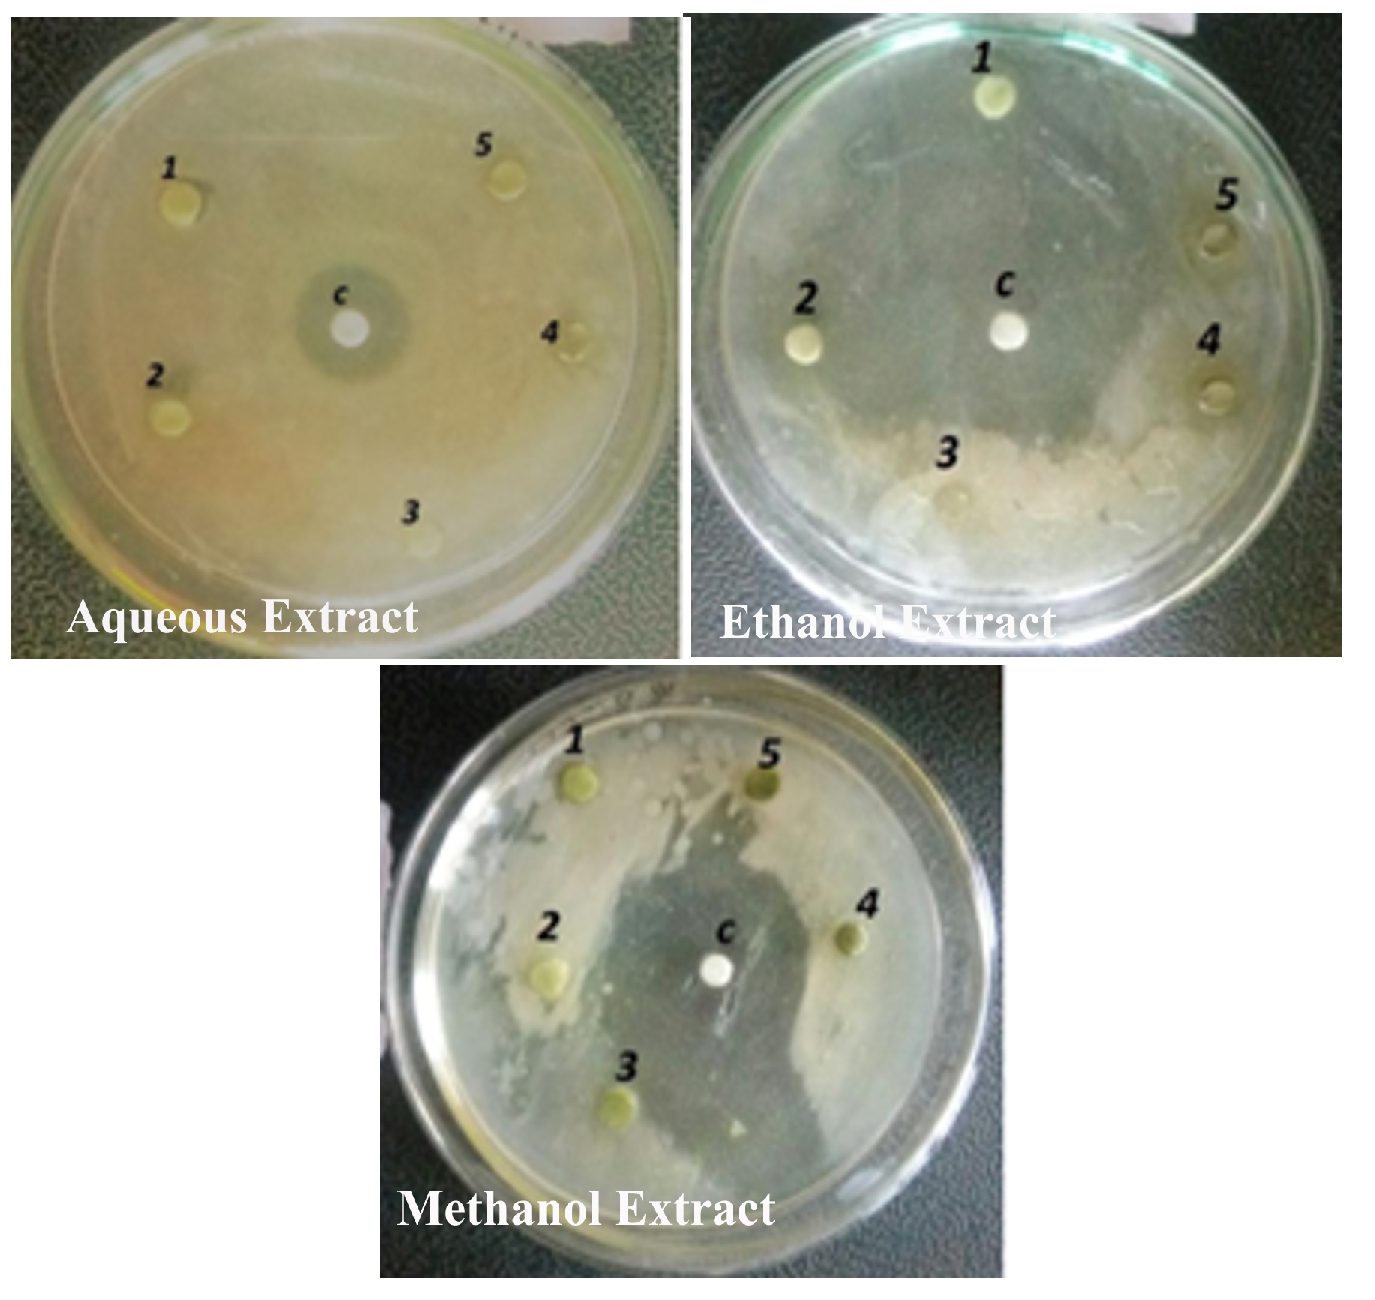

Niranjan MH, Prabhurajeshwar C*
Associate Professor Department of Studies in Biotechnology, Davangere University, Davangere-577007, Karnataka, India
*Address for Corresponding Author
Dr. Prabhurajeshwar
Assistant Professor Department of Studies in Biotechnology, Davangere University, Davangere-577007, Karnataka, India
Abstract
Objective: Alternanthera paronychioides A.St.-Hil. is belongs to the family Amaranthaceae. A native of tropical America becoming widespread as an introduced weed in India, Java and other parts of the old world tropics. The objective of the study of this plant is to determine the bioactive chemical constituents and to evaluate leaf and stem crude extracts for in vitro antimicrobial activities by agar disc diffusion method. Material and methods: Phytochemical analysis of the crude extracts of leaf and stem parts revealed the presence of tannins, saponins, anthraquinones, glycosides, flavonoids and reducing sugar. Results and conclusion: The crude extracts leaf and stem were showed effective against the Staphylococcus aureus, Escherichia coli, Salmonella typhi and Bacillus subtilis. The minimum inhibitory concentrations (MIC) of the crude extracts were determined for the various organisms which ranged between 5.0 and 37.0 mg/ml. These results have showed that Alternanthera paronychioides leaf and stem crude extracts had significant activity against all organisms tested.
Keywords: Alternanthera paronychioides, Phytochemical analysis, Antimicrobial activity, Smooth joy weed
Introduction
The traditional system of herbal medicine are considered as the rich sources of lead compounds which are eco-friendly and quite safe for human use and has become a topic of global importance. The use of plants and plant products as medicines could be traced as far back as the beginning of human civilization. The earliest mention of medicinal use of plants in Hindu culture is founds in “Rig-Veda”, which is said to have been written between 4500-1600 B.C. and is supposed to be the oldest repository of human knowledge. It is Ayurveda, the foundation of medicinal science of Hindu culture, in its eight division deals with specific properties of drugs and various aspects of science of life and the art of healing (Lalitha Sree, 2016). Nearly 80% of the world’s population relies on traditional medicines for primary health care, mast of which involve the use of plant extracts. In India almost 95% of the prescriptions were used in Unani, Ayurveda, Homeopathy and Siddha. Phytochemicals are responsible for medicinal activity of plants. These are non-nutritive chemicals that have protected human from various diseases. The anti-inflammatory, antispasmodic, anti-analgesic and can be attributed to their high steroids, tanning, terpenoids and saponins (Sunil, 2008). India is known for its rich diversity of medicinal plants and from ancient times these plants were utilized as therapeutic agents. Today’s research is mainly focused on medicinal plants because the bioactive compounds and medicinal power mainly depends on phytochemical constituents that have great pharmacological significance (Marcos et al., 2004).
The phytochemical constituents, natural bioactive compounds, nutrients and fibers present in medicinal plants, fruits and vegetables defend us from various ailments. Phytochemicals are classified into two major groups namely primary constituents like amino acids, sugars, proteins and chlorophyll etc. secondary constituents includes alkaloids, essential oils, flavanoids, tannins, terpenoids, saponins and phenolic compounds etc., more over they bear valuable therapeutic activities (Niranjan, 2020).
According to World Health Organization, for their preliminary health care, 80% ofworld’s population depends on traditional medicine.Medicinal properties of several herbal plants and the herbal extracts used to curevariety of diseases are documented in ancient Indian literature. Medicinal value ofthese plants lies in some bioactive substances that produce a definite physiologicalaction on human body (WHO, 2005 and Vimalanalinakumari, 2016). Phytochemicals are not essential nutrients and are required by the human body forsustaining life, but have important properties to prevent or to fight some commondiseases.They protect plants from disease and damage and contribute to the plants color, aroma and flavour. In general, the plant chemicals from environmental hazards such aspollution, stress, drought, UV exposure and pathogenic attack are called asphytochemicals.
Natural products are the source of synthetic and traditional herbal medicine. Themedicinal importance of plant due to the presence of some special substances likealkaloids, glycosides, tannins, flavonoids, saponins etc., Soxhlet apparatus, and crud extraction was used for the organic extraction. Solvents used were petroleum ether, ethyl acetate and methanol (Niranjan, 2020).
Materials and Methods
About Plant
Common name : (Smoothjoyweed)
Division : Magnoliophyta
Class : Rosopsida
Subclass : Caryophyllidae
Order : Caryophyllales
family : Amaranthaceae
genus : Alternanthera
species : AlternantheraparonychioidesA.ST.-HIL.
Plant Description
Habitat: Herbs, perennial, 1-8 dm
Stem: Stems prostrate, villous and glabrate.
Leaves: Sessile; blade elliptic, ovate-rhombic, or oval, 0.6-2.5 × 0.3-1.1cm, apex acute or obtuse, villous, soon glabrate Inflores-cences: axillary, sessile; heads white, globose, 0.5-1cm diam.; bracts lessthan 1/2 as long as tepals. Flower:-tepals monomorphic, white, lanceolate, 3-5mm, apex acuminate, without rigid, spinose tips, hairs not barbed; stamens 5; anthers 3-5, globose;pseudostaminodesligulate, shorter than filaments, margins entire or dentate. Utricles included within tepals, stramineous, orbiculate to rounded-obovate, 2-2.3mm, apex truncate.
Seeds: Lenticular, 1.2-1.5mm.
Uses: In Sri Lanka, the plant is used in salads. They also use it for the treatment ofbiliousness, dyspepsia and sluggish liver. Alternanthera paronychioides is used in local medicine in Taiwan, along with other medicinal plants, to treat hepatitis, tightchest, bronchitis, asthma and other lung troubles. Alternanthera paronychioides protects pancreatic β-cells from glucotoxicity by its antioxidant, antiapoptotic and insulin secretagogue actions.
Plant Collection
Collection of plant material Fresh and healthy ,disease free, leaves of Alternanthera paronychioideswere collected from Thadimalngi, T. Narasipura taluk, Mysore district, Karnataka state, India (Figure 1).
Figure 1. Habitat of Alternanthera paronychioides A.ST.-HIL
Preparation of leaf and stem extracts
The aerial parts of plant fresh leaves and stem of Alternanthera paronychioides leaves were 2 times washed thoroughly under running tap water and at last rinse with sterile distilled water to remove the dirt and dried .under shade dried at room
temperature.The dried leaves were powdered in a blender leaves were powder in a blender or mixer grinder until fine coarse powder obtained and stored in air tight container at stored in room temperature and them used for crude extraction (Ramamurthy, 2013),(Figure 2).
Figure 2. A. Alternanthera paronychioides leaves; B: Alternanthera paronychioides stem C: A. paronychioides leaves powder; D: A. paronychioides stem powder
A. paronychioidesleaves and stem extract using three types of solvents (methanol, ethanol, aqueous).Fine powder of leaves and stem (40gm) was extracted in 100 ml of ethanol, methanol, aqueous at 50-55°C for 24 hours in rotary shaker. The extract was filtered through Whatman filter paper No.1 and then concentrated by using a rotary evaporator at low temperature (40-50°C) and reduced pressure. Further, the driedresidue was preserved in airtight container and kept at 4-5°C until further use (Tiwari, 2011; Keener, 2021).
Yield of extracts
After the concentrate extract obtained from the rotary evaporator, they were collected in the vials. Extract were dried in the room temperature until the dried powder left in vials. Each vial is weighed to calculate the plant extract in the dry form. From that dry form one gram of dried powder is diluted in 10 ml of respective solvents to test against microorganisms at different concentration (Sukanya, 2009).
Phytochemical test
Different extracts of Alternanthera paronychioides leaves and stem were subjectedto phytochemical analysis to detect the presence of some active chemical compound. Chemical test were carried out to identity the presence of phytoconstituents in ether, methanol, aqueous extracts using standard procedure of Ahmad, 2001 and Niranjan, 2020, following qualitative tests were conducted in the laboratory to confirm pressure and absence of phytoconstituents.
Test for Carbohydrates
Benedict Test: 1ml of extract was treated with Benedict’s reagent and heated gently orange red precipitate indicates presence of reducing sugar.
Test for Saponins
Froath test: Extract was treated with distil water to 20 ml and this was shaken in graduated cylinder for 15 min resulting in the formation of 1cm layer of foam indicates the presence of saponins.
Test for Tannins
Iodinetest: Leaves and bark extract were treated with dil Iodine solution andappearance of transient red color indicates presence of tannins.
Test for Proteins
Biuret test: Leaves and bark extracts were treated with 1ml NaOH (10%) solution is added. A violet color indicates the presence of proteins.
Test for alkaloids
Take 500mg of leaf powder and stirred with 5 ml of dilute.HCL filtered and each testin done by following process.
Hager’stest: A filtrate was treated with hanger’s reagent saturated picric acid solution, in the presence of alkaloids conformed by formation yellow color precipitate.
Test for Flavonoids
Lead acetate: Extract was treated with few drops of lead acetate solution. Formation of yellow color precipitate indicates the presence of flavonoids.
Test for Glycoside: 0.2 g of extract is dissolved in 1 ml of glacial acetic acid containing 1 drop of ferricchloride solution then 1 ml of concentration sulphuric acid is added slowly. A brownring obtained at the interforce indicates the presence of glycosides.
Test for Anthraquinones test: About 0.5g of extracts was taken in test tube and 5 ml of chloroform was added andshaken for 5 min. The extracts were filtered. The filtered shaken with equal volume of10% ammonia solution .A pink violet/ red color in the ammonia layer indicates the presence of anthraquinones.
Antimicrobial Activity of Alternanthera paronychioides A. ST.-HIL. leaves and stem
Antimicrobial assay of extracts of different plants was performed by agar well diffusion method in Mueller Hinton Agar (MHA) plates. The test organismswere obtained from Department of Botany, Manasa Gangotri Mysore, inoculated in Nutrient broth and incubated overnight at 37°C to adjust the turbidity to 0.5 McFarland standards solution. MHA plate was lawn cultured with standardized microbial culture broth. Plant extracts of 50 mg/ml concentration were prepared; wells of 6 mm were bored in the inoculated media with the help of sterile cork-borer. Each well was filled with 50 μl extracts from different plants: with positive and negative control respectively. It was allowed to diffuse for about 30 minutes at room temperature and incubated for 18-24 hours at 37°C. After incubation, plates were observed for the formation of a clear zone around the well which corresponds to the antimicrobial activity of tested compounds. The zone of inhibition (ZOI) was observed and measured in mm (Niranjan, 2020).
Results and Discussion
Phytochemical studies
The preliminary qualitative phytochemical screening of leaf and stem extract showed the presence of phytochemical substances such as ethanol, aqueous and methanol extracts indicated the presence of alkaloids, Anthraquinones, proteins flavonoids, saponins, tannins, carbohydrates and reducing sugar Anthraquinones. Phytochemicals or secondary metabolites usually occur in complex mixtures that different among plant organs and stages of development.
Knowledge of the phytochemical constituents present in A. paronychioides is very useful for the maximum exploitation of this plant in medicine. Preliminary phytochemical screening of A. paronychioides leaf and stem extracts revealed the presence of various bioactive compounds and the results were summarized in Table 1 and 2.
Table 1. Preliminary Phytochemical Screening of Alternanthera paronychioidesA.ST.HIL. Leaves
|
Sl. No |
Test |
Solvents |
||
|
Aqueous |
Ethanol |
Methanol |
||
|
1 |
Carbohydrates |
++ |
+ |
++ |
|
2 |
Saponins |
+ |
+ |
+ |
|
3 |
Tannins |
+ |
+ |
+ |
|
4 |
Proteins |
- |
- |
- |
|
5 |
Alkaloids |
+ |
- |
- |
|
6 |
Flavonoids |
- |
- |
- |
|
7 |
Glycoside |
+++ |
+++ |
+++ |
|
8 |
Anthraquinones |
- |
- |
+ |
|
9 |
Reducing sugar |
++ |
+ |
+ |
Note:-(- = Absent, + = Present,), (+ = Minimum,++ = Moderate,+++ = Maximum)
Table 2. Preliminary Phytochemical Screening of lternanthera paronychioides A.ST.HIL.stem
|
Sl. No |
Test |
Solvents |
||
|
Aqueous |
Ethanol |
Methanol |
||
|
1 |
Carbohydrates |
++ |
++ |
++ |
|
2 |
Saponins |
+ |
+ |
+ |
|
3 |
Tannins |
+ |
+ |
+ |
|
4 |
Proteins |
- |
- |
- |
|
5 |
Alkaloids |
+ |
- |
- |
|
6 |
Flavonoids |
- |
- |
- |
|
7 |
Glycoside |
+++ |
+++ |
+++ |
|
8 |
Anthraquinones |
- |
- |
+ |
|
9 |
Reducing sugar |
+ |
++ |
+ |
Note: - (- = Absent, + = Present,), (+ = Minimum, ++ = Moderate, +++ = Maximum)
The phytochemical screenings of A.paronychioides. shows the presence carbohydrates, saponins, tannins, glycoside, reducing sugar of all major phytochemicals of in appreciable amount and other components in moderate amount. Whereas flavonoids, protein, and are absent. The maximum result in glycoside both leaves and stem extract of A.paronychioides and moderate results shown in reducing sugar, in aqueous leaves extract and stem ethanol extract .Preliminary phytochemical screening of A. paronychioides shown both stem and leaves, Aqueous extract present in alkaloids, anthraquinones shown both stem and leaves methanol extract present, absent in aqueous and ethanol extract (Doughari, 2009; Laxmi, 2017).
Preliminary phytochemical surveys and the knowledge of the chemical constituents of plants are desirable to understand herbal drugs and their preparations. Therefore, the phytochemical investigation of A. Paronychioides leaves and stem in the present study reveals the presence of various potential phytochemical constituents which may be useful for pharmaceutical industries and could be used as an effective nutraceuticals. The presence of these phytochemicals is an indicator, that the plant can be a potential source of precursors in the development of synthetic drugs. Antibiotics are one of the most important weapons that fight against bacterial and fungal infections. The human life has been benefited since the introduction of antimicrobial agents.
Antimicrobial Activity
The antibacterial activity of the aqueous extract of A.paronychioides, the highest inhibitory effect to the extract was observed on Staphylococcus aureus (Figure 3 and Table3), leaf extract with a zone of inhibition of 40 mm while Bacillus subtilis (Figure 6 and Table 6) leaves ethanol and methanol extract was the least inhibited with a zone of inhibition of ethanol 40 mm, methanol 30-50mm. Antibacterial activity of the Aqueous extract of A. paronychioides the highest inhibitory effect to extract was observed on Salmonella typhi (Figure 9 and Table 9), stem extract with a zone of inhibition 50mm while Bacillus subtilis (Figure 10 and Table 10). Stem ethanolic extract was least inhibited with a zone of inhibition of 30mm Plants of the genus Alternanthera are thought to possess antimicrobial and antiviral properties (Sunil et al., 2008), reported that the wound healing property, nosocomial infection, food borne illness (Cheikna, 2011).
Table 3. Antibacterial activity of A. paronychioidesleaves ofdifferent solvent extract against Staphylococcus aureus.
|
Sl. No |
Extract Used |
Zone of Inhibition (in cm)/Concentration in µg/ml |
|||||
|
control |
10 |
20 |
30 |
40 |
50 |
||
|
1 |
Aqueous |
10.16±1.25 |
16.40±0.52 |
12.26±0.46 |
37.86±0.32 |
52.66±5.03 |
46.66±2.08 |
|
2 |
Ethanol |
32.26±0.30 |
22.1±0.36 |
26±2 |
42.23±0.68 |
29.8±0.72 |
30±1 |
|
3 |
Methanol |
40±1 |
5.96±0.85 |
13.5±0.5 |
27.16±1.60 |
29.3±0.51 |
24.8±0.81 |
Note: Values are represented as mean diameter of zone of inhibition in triplicates ± standard deviation (P<0.001).

Figure 3. Antibacterial activity of Alternanthera paronychioidesA.St.-Hil.leaves against Staphylococcus aureus
Table 4. Antibacterial activity of A. paronychioidesleaves ofdifferent solvent extract against Escherichia coli
|
Sl. No |
Extract Used |
Zone of Inhibition (in cm)/Concentration in µg/ml |
|||||
|
control |
10 |
20 |
30 |
40 |
50 |
||
|
1 |
Aqueous |
39.93±0.6 |
2.66±0.32 |
12.06±0.20 |
17.96±0.05 |
26±0.2 |
32.3±0.60 |
|
2 |
Ethanol |
0.00 |
8.75±0.17 |
10.4±0.78 |
4.03±0.06 |
12±0 |
24.8±0.55 |
|
3 |
Methanol |
56.6±0.3 |
14.8±2.17 |
17.96±0.05 |
20.13±0.32 |
12±0 |
27.13±0.23 |
Note: Values are represented as mean diameter of zone of inhibition in triplicates ± standard deviation (P<0.001).
Figure 4. Antibacterial activity of Alternanthera paronychioidesA.St.-Hil.leaves against Escherichia coli
Table 5. Antibacterial activity of A. paronychioidesleaves ofdifferent solvent extract against Salmonella typhi
|
Sl. No |
Extract Used |
Zone of Inhibition (in cm)/Concentration in µg/ml |
|||||
|
control |
10 |
20 |
30 |
40 |
50 |
||
|
1 |
Aqueous |
50.16±0.15 |
18±0 |
19.63±0.55 |
10.06±0.20 |
28±0 |
40.16±0.76 |
|
2 |
Ethanol |
53.66±0.57 |
23.93±0.05 |
18±0 |
22.1±0.26 |
24.13±0.321 |
30.32±0.57 |
|
3 |
Methanol |
22.1±0.20 |
34.13±0.15 |
15.96±0.05 |
20.13±0.41 |
12.04±0.16 |
8.13±0.83 |
Note: Values are represented as mean diameter of zone of inhibition in triplicates ± standard deviation (P<0.001).
Figure 5. Antibacterial activity of Alternanthera paronychioidesA.St.-Hil.leaves against Salmonella typhi
Table 6. Antibacterial activity of A. paronychioidesleaves of different solvent extract against Bacillus substilis
|
Sl. No |
Extract Used |
Zone of Inhibition (in cm)/Concentration in µg/ml |
|||||
|
control |
10 |
20 |
30 |
40 |
50 |
||
|
1 |
Aqueous |
38.13±0.23 |
24±0 |
28.06±0.20 |
20±0 |
26.16±0.65 |
34.13±0.32 |
|
2 |
Ethanol |
0.0 |
24±0 |
6.1±0.26 |
2.03±0.25 |
0.0 |
8±0 |
|
3 |
Methanol |
71.16±0.15 |
6.06±0.20 |
4.13±0.70 |
0.0 |
2.13±0.70 |
0.0 |
Note: Values are represented as mean diameter of zone of inhibition in triplicates ± standard deviation (P<0.001).
Figure 6. Antibacterial activity of Alternanthera paronychioidesA.St.-Hil.leaves against Bacillus subtilis
Table 7. Antibacterial activity of A. paronychioidesstem of different solvent extract against Staphylococcus aureus
|
Sl. No |
Extract Used |
Zone of Inhibition (in cm)/Concentration in µg/ml |
|||||
|
control |
10 |
20 |
30 |
40 |
50 |
||
|
1 |
Aqueous |
61±3.60 |
16.13±0.32 |
6±0 |
9±1 |
19.96±0.05 |
32.06±0.20 |
|
2 |
Ethanol |
50±0.7 |
11.46±0.50 |
22.1±0.26 |
2±0 |
22.6±0.55 |
32.6±0.52 |
|
3 |
Methanol |
39.93±0.50 |
6±0 |
10.4±0.26 |
15.93±0.11 |
16.53±0.50 |
20.26±0.30 |
Note: Values are represented as mean diameter of zone of inhibition in triplicates ± standard deviation (P<0.001).
Figure 7. Antibacterial activity of Alternanthera paronychioidesA.ST.-HIL. Stem against Staphylococcus aureus
Table 8. Antibacterial activity of A. paronychioidesstem of different solvent extract against Escherichia coli
|
Sl. No |
Extract Used |
Zone of Inhibition (in cm)/Concentration in µg/ml |
|||||
|
control |
10 |
20 |
30 |
40 |
50 |
||
|
1 |
Aqueous |
59.76±0.68 |
23.93±0.11 |
19.96±0.05 |
17.93±0.05 |
29.86±0.15 |
8.23±0.15 |
|
2 |
Ethanol |
27.93±0.40 |
12.36±0.40 |
3.1±0.1 |
20.3±0.60 |
32±0 |
43.06±0.40 |
|
3 |
Methanol |
0.00 |
37.93±0.05 |
20±1 |
14.8±0.1 |
9.9±0.1 |
42±0 |
Note: Values are represented as mean diameter of zone of inhibition in triplicates ± standard deviation (P<0.001).

Figure 8. Antibacterial activity of Alternanthera paronychioidesA.ST.-HIL. Stem against Escherichia coli.
Table 9. Antibacterial activity of A. paronychioidesstem of different solvent extract against Salmonella typhii
|
Sl. No |
Extract Used |
Zone of Inhibition (in cm)/Concentration in µg/ml |
|||||
|
control |
10 |
20 |
30 |
40 |
50 |
||
|
1 |
Aqueous |
38.56±0.35 |
20.03±0.55 |
32.13±0.23 |
35.96±0.05 |
35.96±0.05 |
50.13±0.32 |
|
2 |
Ethanol |
52.2±0.52 |
20.03±0.55 |
30.93±0.35 |
26.3±0.51 |
28.06±0.20 |
30.16±0.20 |
|
3 |
Methanol |
26±0 |
9.93±0.05 |
14±0 |
26.3±0.51 |
29.96±0.05 |
7.96±0.05 |
Note: Values are represented as mean diameter of zone of inhibition in triplicates ± standard deviation (P<0.001).

Figure 9. Antibacterial activity of Alternanthera paronychioidesA.ST.-HIL. Stem against Salmonella typhii
Table 10. Antibacterial activity of A. paronychioidesstem of different solvent extract against Bacillus substilis
|
Sl. No |
Extract Used |
Zone of Inhibition (in cm)/Concentration in µg/ml |
|||||
|
control |
10 |
20 |
30 |
40 |
50 |
||
|
1 |
Aqueous |
79.9±0.05 |
18.06±0.20 |
22.1±0.17 |
3.96±0.05 |
10.03±0.15 |
13.13±0.70 |
|
2 |
Ethanol |
31.16±0.37 |
12.16±0.37 |
18.23±0.25 |
0.0 |
15.96±0.05 |
9.96±0.05 |
|
3 |
Methanol |
74.66±5.03 |
24.96±0.057 |
3.5±0 |
25.96±0.05 |
29.93±0.11 |
30.1±0.36 |
Note: Values are represented as mean diameter of zone of inhibition in triplicates ± standard deviation (P<0.001).
Figure 10. Antibacterial activity of Alternanthera paronychioidesA.ST.-HIL. Stem against Bacillus substilis
A. paronychioide might be due to the inhibitory effect of the plant extract observed in Staphylococcus aureus and Escherichia coli, Salmonella typhi, Bacillus subtilis and were not susceptible to the extract. This might be due to the inability of the active components in the plant extract to inhibit these organisms. Srilanka used for tradition medicinal plant, also use it for the treatment of biliousness, dyspepsia and sluggish liver. Alternanthera paronychioides is used in local medicine to treat hepatitis, tight chest, bronchitis, asthma and other lung troubles. A. paronychioides protects pancreatic β cells from glucotoxicity by its antioxidant, antiapoptotic and insulin secretagogue actions (Kumari, 2016).
Conclusion
This study showed that A. Paronychioides has antibacterial activity against, Staphylococcus aureus, Escherichia coli, Salmonella typhi and Bacillus subtilis as verified by the in vitro experiments. The present study establishment of A. Paronychioides from leaf and stem plant. This is the first report on phytochemical analysis and antimicrobial activity. This is an indication that A. Paronychioides can be possibly used for the treatment of wound and antibacterial activity of aqueous extract of A. Paronychioides showed broad inhibitory effects on the test isolates. Further purification may enhance greater antibacterial potency. This work has however not included the toxicological analysis for more antibacterial effectively as in the case of commercial antibiotics, and more research should be conducted on other medicinal plants that can act synergistically with A. paronychioides. Both the plants showed positive results of different secondary metabolites such as, tannins, saponins, glycosides are of medicinal importance and carbohydrates, Reducing sugar are rich source of nutritional value.Further, A. Paronychioides seems to be held great potential for in depth investigation for various biological activities and the obtained through this work may be useful in developing new formulation with more therapeutic value. So the plant extract could be used as drugs for various ailments, which can be studied in future studies.
Acknowledgments
The authors are profusely thankful to the Department of Biotechnology, Davangere University, Davangere for providing facilities.
Conflict of interest statement
We declare that no conflict of interest.
References
Ahmad I, Beg AZ. 2001. Antimicrobial and phytochemical studies on 45 Indian medicinal plants against multi-drug resistant human pathogens. Journal of Ethno pharmacology, 74:113-123.
Cheikna Z, Savadogo A, Somda M, Koudou J. 2011. In vitro evaluation of the antimicrobial and antioxidant properties of extracts from whole plant of Alternanthera pungens H.B. & K. and leaves of Combretum sericeum G. Don. International Journal of Phytomedicine, 3:182-191.
Doughari JH, Human IS, Bennade S, Ndakidemi PA. 2009. Phytochemicals as chemotherapeutic agents and antioxidants. Possible solution to the control of antibiotic resistant verocytotoxins producing bacteria. Journal of Medicinal Plants Research, 3 (11):839-848.
Keener D, Diamond A, Davenport L, Davison P, Ginzbarg S, Hansen C, Major C, Spaulding D, Triplett J, Woods M. 2021. Alabama Plant Atlas, 439
Kumari, Krishnan V. 2016. Antimicrobial Activity of Alternanthera Sessilis (L) R. BR. Ex. DC and Alternanthera Philoxeroides (Mart). Griseb. World Journal of Research and Review, 3(3):78-81.
Lalitha Sree T, Vijayalakshmi K. 2016. Phytochemical screening and quantitative analysis of bioactive components in various extracts of Alternanthera sessilislinn Leaves. International Journal of Chemistry and Pharmaceutical Sciences, 42-246.
Laxmi S, Zarafsha A. 2017. A Review on Alternanthera Sessilis. Indo American Journal of Pharmaceutical Sciences, 4(9):2845-2852.
Marcos j, Salvadorl, Paulo S, Pereira, Suzelei, França, Regina C, Candido i. 2004. Comparative study of antibacterial and antifugal activity of callus Culture and adult plants extracts from Alternanthera maritime (amaranthaceae). Brazilian Journal of Microbiology, 131-136.
Niranjan MH, Prabhurajeshwar. 2020. “Phytochemicals Analysis and Antimicrobial activity of leaf and stem of Ipomoea staphylina Roem. &Schult”. International Journal of Research in Pharmaceutical Sciences, vol 11(3).
Niranjan MH, Prabhurajeshwar. 2020. Phytochemical Analysis and Antimicrobial Activity of Leaf and Stem Extracts of Priva cordifolia (L.f.) Druce”. European Journal of Medicinal Plants, 31(7):42-53.
Ramamurthy V, Maria Rajeshwari D, Gowri R, Vadivazhagi MK, Jayanthi G, Raveendran S. 2013. Study of the phytochemical analysis and Antimicrobial activity of dodonaea viscose. International Journal of Pure and Applied Zoology, 1(2):178-184.
Sukanya S, Sudisha J, Hariprasad P, Niranjana S, Prakash H, Fathima S. 2009. Antimicrobial activity of leaf extracts of Indian medicinal plants against clinical and phytopathogenic bacteria. African Journal of Biotechnology, 8 (23):6677-6682.
Sunil S, Jalalpure, Agrawal N, Patil MB, Chimkode R, Tripathi A. 2008. Antimicrobial and wound healing activities of leaves of Alternanthera sessilislinn. International Journal of Green Pharmacy, 141-144.
Tiwari P, Kumar H, Kaur M, Kaur G. 2011. Phytochemicals screening and Extraction: A Review. International Pharmaceutical Science, (1):98-106.
Vimalanalinakumari E, Krishnan V. 2016. Qualitative and quantitative estimation of phytochemicals of Alternanthera sessilis (l) r. Br. Ex. Dc and Alternanthera Philoxeroides (mart). Griseb. International Journal of Botany and Research (IJBR) Vol. 6(4):29-34.
World Health Organization. 2005. WHO Policy Perspectives on Medicines-containing antimicrobial resistance, WHO/PSM/2005.1, Geneva.